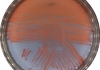

전라남도의회 정영균 도의원, “학교용지부담금 사용처 확대 필요”
예산 형해화 방지와 통학환경 및 학생 안전 개선 위해 제도 개선 시급
입력 : 2025. 11. 27(목) 11:17

정영균 의원 예산결산특별위원회에서 질의 모습
[시사토픽뉴스]전라남도의회 정영균 의원(더불어민주당, 순천1)이 지난 11월 26일 열린 전라남도 추가경정예산안 심사에서 학교용지부담금의 지속적인 집행 지연 문제를 지적하며, “학교용지부담금의 사용 목적을 확대해 실질적인 교육환경 개선에 활용해야 한다“고 강조했다.
정영균 의원은 “매년 학교용지부담금을 편성해 놓고도 집행하지 못하는 상황이 반복되고 있다”며 “이러한 구조는 예산의 실효성을 떨어뜨리고, 다른 교육 분야에 투자할 기회를 상실하게 만드는 예산 형해화 문제”라고 지적했다.
이에 대해 강종철 인재육성국장은 “학교 설립을 위해 편성된 부담금이지만, 교육청의 사업 진행 일정이 늦어지면서 집행 시기가 지연되고 있다”며, “올해도 교육청이 사업 추진이 어렵다는 의견을 보내와 내년으로 이월될 예정이며, 통합재정안정화기금을 거쳐 다시 집행할 계획”이라고 설명했다.
정영균 의원은 “학교용지부담금 관련 조례를 보면 학교 증․개축에 사용할 수 있는 근거가 이미 마련돼 있다”며, “신설 학교 부지 확보 외에도 교육환경개선․학생 안전․통학환경 개선 등 다양한 분야로 사용처를 확대할 필요가 있다”고 재차 강조했다.
이어 정영균 의원은 “도 교육청과의 협의는 물론 교육부 등 관계부처에 제도 개선을 적극 건의해야 한다”고 주문했다.
현재 학교용지부담금은 학교 신설을 위한 부지 확보에 한정되어 있으나, 학령인구 감소로 신규 학교 설립이 지연되어 부담금 집행률은 낮아지고, 지방재정 비효율 문제가 반복되고 있다는 지적이 제기되고 있다.
마지막으로 정영균 의원은 “지역 교육환경 변화에 맞는 유연한 재정 운영이 필요하다”며, “학교용지부담금이 실제 학생과 학부모가 체감할 수 있는 교육환경 개선에 쓰일 수 있도록 중앙정부 차원의 제도 개선이 반드시 필요하다”고 거듭 강조했다.
 최준규 기자
최준규 기자
정영균 의원은 “매년 학교용지부담금을 편성해 놓고도 집행하지 못하는 상황이 반복되고 있다”며 “이러한 구조는 예산의 실효성을 떨어뜨리고, 다른 교육 분야에 투자할 기회를 상실하게 만드는 예산 형해화 문제”라고 지적했다.
이에 대해 강종철 인재육성국장은 “학교 설립을 위해 편성된 부담금이지만, 교육청의 사업 진행 일정이 늦어지면서 집행 시기가 지연되고 있다”며, “올해도 교육청이 사업 추진이 어렵다는 의견을 보내와 내년으로 이월될 예정이며, 통합재정안정화기금을 거쳐 다시 집행할 계획”이라고 설명했다.
정영균 의원은 “학교용지부담금 관련 조례를 보면 학교 증․개축에 사용할 수 있는 근거가 이미 마련돼 있다”며, “신설 학교 부지 확보 외에도 교육환경개선․학생 안전․통학환경 개선 등 다양한 분야로 사용처를 확대할 필요가 있다”고 재차 강조했다.
이어 정영균 의원은 “도 교육청과의 협의는 물론 교육부 등 관계부처에 제도 개선을 적극 건의해야 한다”고 주문했다.
현재 학교용지부담금은 학교 신설을 위한 부지 확보에 한정되어 있으나, 학령인구 감소로 신규 학교 설립이 지연되어 부담금 집행률은 낮아지고, 지방재정 비효율 문제가 반복되고 있다는 지적이 제기되고 있다.
마지막으로 정영균 의원은 “지역 교육환경 변화에 맞는 유연한 재정 운영이 필요하다”며, “학교용지부담금이 실제 학생과 학부모가 체감할 수 있는 교육환경 개선에 쓰일 수 있도록 중앙정부 차원의 제도 개선이 반드시 필요하다”고 거듭 강조했다.